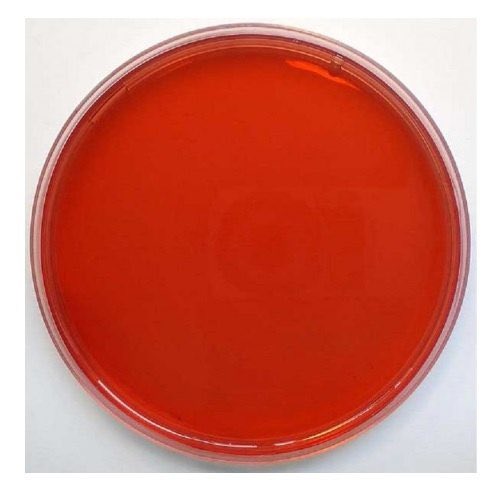

طيب شنو الاختبارات اللي أسويها وممكن تساعدني؟
أول شيء بستخدم ميديا خاصة بالبكتيريا السالبة الجرام واللي اسمها MacConky agar
شنو فكرة هالميديا اللطيفة؟ هي عبارة عن ميديا نستخدمها كَ selective + differential
أول شيء بستخدم ميديا خاصة بالبكتيريا السالبة الجرام واللي اسمها MacConky agar
شنو فكرة هالميديا اللطيفة؟ هي عبارة عن ميديا نستخدمها كَ selective + differential
بنعتبرها selective لانها بتثبط نمو أي باكتيريا غير الباكتيريا السالبة الجرام ونعتبرها differential لأنها بتفرق لي بين أفراد هالعايلة اللي قادرين يخمرون اللاكتوز وبين الأفراد اللي مايقدرون يخمرون اللاكتوز
اللي بِتقدر تخمر اللاكتوز بتطلع حمض وبعدها بيتغير اللون إلى الأحمر ومن أمثلة الباكتيريا اللي تقدر تخمر اللاكتوز: E.coli, klebsiella وتعتبر من الباكتيريات اللي وجودها طبيعي في القولون ومُفيد لكن في حال راحت مكان غير بتصير خطيرة
طبعاً فيه تستات للسالمونيلا ممكن أسويها بعد مثل: motility test وطبعاً السالمونيلا متحركة
فيه بعد biochemical test عشان أشوف هل هي تنتج حمض أو حمض وغاز " يساعدني في التفريق بين أنواع السالمونيلا "
وبعد فيه Slide Agglutination test
فيه بعد biochemical test عشان أشوف هل هي تنتج حمض أو حمض وغاز " يساعدني في التفريق بين أنواع السالمونيلا "
وبعد فيه Slide Agglutination test
طيب فيه كلمة بتساعدنا بَعد اللي هي “ IMVIC TESTS “ هالكلمة عِبارة عن اختصار لأربعة تستات مِختلفة
📌 Indole test
📌 Methyl red
📌 Vogas, prosakaur
📌 Citrate test
خَلينا نتعرف عليهم واحد واحد 🤩
📌 Indole test
📌 Methyl red
📌 Vogas, prosakaur
📌 Citrate test
خَلينا نتعرف عليهم واحد واحد 🤩
نجي لأولهم واللي هو Indole test
فيه بعض الباكتيريا عندها انزيم اسمه tryptophanase ومنه بتقدر تحول امينو اسيد اسمه tryptophan إلى Indole ومركبات ثانية
فيه بعض الباكتيريا عندها انزيم اسمه tryptophanase ومنه بتقدر تحول امينو اسيد اسمه tryptophan إلى Indole ومركبات ثانية
طيب نجي للي بعده اللي هو Methyl red هِنا عندي جلوكوز في الميديا
اذا كان فيه تخمير للجلوكوز بتعطيني حمض والحمض يقلل PH وتزداد حموضة الميديا وفيه كاشف اسمه methyl red indicator بيعطيني اللون الأحمر.
مثال: E.coli.
اذا كان فيه تخمير للجلوكوز بتعطيني حمض والحمض يقلل PH وتزداد حموضة الميديا وفيه كاشف اسمه methyl red indicator بيعطيني اللون الأحمر.
مثال: E.coli.
وآخر جزء من الكلمة هو citrate utilization test
هنا بنستخدم ميديا فيها الستريت فقط كمصدر لِ co2 وبنشوف هل الباكتيريا قادرة على استخدام الستريت ولالا؟
هنا بنستخدم ميديا فيها الستريت فقط كمصدر لِ co2 وبنشوف هل الباكتيريا قادرة على استخدام الستريت ولالا؟
لو كانت قادرة انها تستخدم الستريت راح تحوله إلى البايرفيت وبعدها Co2 يتفاعل مع الصوديوم والماء ويتحول الى البايكربونيت " قاعدي " يعني بيرفع PH وبتصير الميديا قاعدية وفيه كاشف اسمه bromothymol blue اذا صار اللون ازرق معناها النتيجة +
فيه بعد تست إسمه urease test
هنا راح نستخدم ميديا تحتوي على urea + phenol red
فيه بعض الباكتيريا عندها القدرة على انتاج انزيم إسمه urease وبيحول اليوريا إلى ثاني اكسيد الكربون + أمونيا
هنا راح نستخدم ميديا تحتوي على urea + phenol red
فيه بعض الباكتيريا عندها القدرة على انتاج انزيم إسمه urease وبيحول اليوريا إلى ثاني اكسيد الكربون + أمونيا
هِنا بدرج المقطعين اللي استفدت منهم جِداً واقتبست شرحي منهم، وأتمنى يكون مفهوم للجميع 💜💜
m.youtube.com
m.youtube.com
جاري تحميل الاقتراحات...